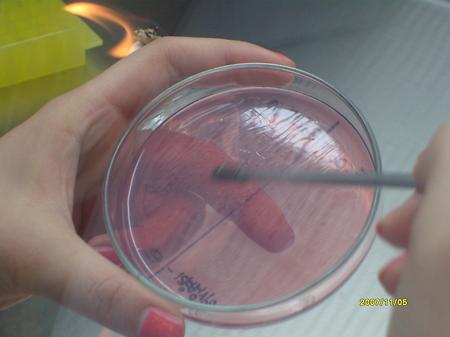

-
[2008년] 균별 용혈능 관찰2021-06-28 김영림 5103
-
[2008년] MSA 배지 접종 결과2021-06-28 김영림 5599
-
[2007년] 임상병리학과 초청 세미나2021-06-28 김영림 3429
-
[2007년] 미생물학 실험2021-06-28 김영림 3333
-
[2007년] 자연과학대학 학술발표대회2021-06-28 김영림 3588
-
[2007년] 미생물 배양 배지 제조 22021-06-28 김영림 3395
-
[2007년] 엠티2021-06-28 김영림 3026
-
[2007년] 미생물 배양 배지 제조 12021-06-28 김영림 3230
-
[2007년] 학과실 OPEN2021-06-28 김영림 2953
-
[2007년] DNA 조각상2021-06-28 김영림 2864
-
[2007년] 1학기 개강총회2021-06-28 김영림 3015
-
[2007년] 체육대회2021-06-28 김영림 3074